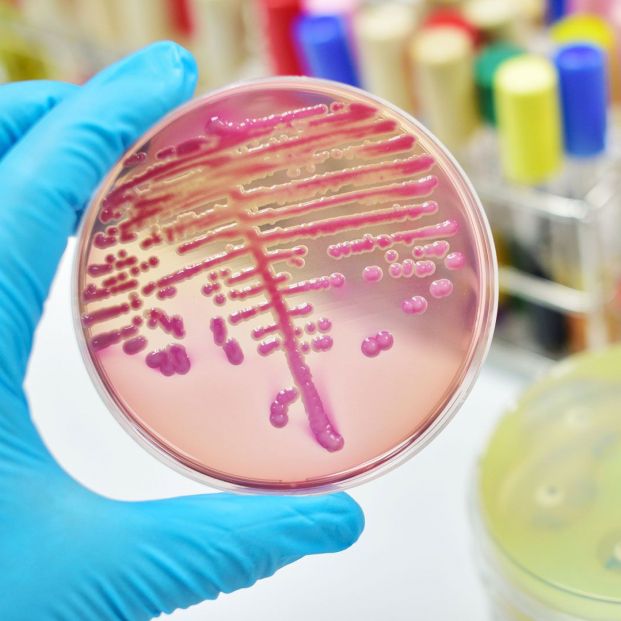
Bacterias Klebsiella oxytoca

Diferencias entre enfermedades víricas y bacterianas
Para evitar la transmisión de virus y bacterias, hay que evitar tocarse la cara, la boca o la nariz

Las bacterias y los virus pueden causar muchas infecciones comunes, pero, ¿cuáles son las diferencias entre estos dos tipos de organismos infecciosos? Las bacterias son microorganismos diminutos que están formados por una sola célula. Son muy diversos y pueden tener una gran variedad de formas y características estructurales. Además pueden vivir en casi todos los entornos imaginables, incluso dentro o sobre el cuerpo humano. Solo algunas de ellas causan infecciones en humanos, las que se conocen como patógenas.
Los virus son otro tipo de microorganismo diminuto, aunque son incluso más pequeños que las bacterias. Al igual que estas, son muy diversos y tienen una variedad de formas y características. Son parásitos, lo que significa que requieren células vivas o tejido en el cual crecer. Pueden invadir las células del cuerpo, utilizando los componentes de estas para crecer y multiplicarse. Algunos incluso matan las células huésped como parte de su ciclo de vida.
¿Cómo se propagan las infecciones bacterianas?
Muchas infecciones bacterianas son contagiosas, lo que significa que se pueden transmitir de persona a persona. Según la Organización Mundial de la Salud (@opsoms), hay muchas maneras en que esto puede ocurrir, como el contacto cercano con una persona que tiene una infección bacteriana, tocándola o besándola. También con los fluidos corporales de una persona infectada, particularmente después del contacto sexual, o cuando una persona infectada tose o estornuda.
La transmisión de madre a hijo durante el embarazo o el parto es otra posibilidad, al igual que entrar en contacto con superficies contaminadas, como pomos de las puertas o manijas de las llaves, y luego tocarse la cara, la nariz o la boca. Además de propagarse entre personas, las bacterianas también se pueden transmitir a través de la picadura de un insecto infectado. El consumo de alimentos o agua contaminados también puede provocar infecciones.
Algunos ejemplos de estas infecciones incluyen la faringitis estreptocócica, la infección del tracto urinario, la intoxicación alimentaria bacteriana, la gonorrea, la tuberculosis, la meningitis bacterial, la celulitis, la enfermedad de Lyme y el tétanos.

¿Cómo se transmiten las infecciones virales?
Al igual que las anteriores, muchas infecciones virales también son contagiosas. Se pueden transmitir entre personas de muchas de las mismas maneras como entrar en contacto cercano con una persona que tiene una infección viral o con los fluidos corporales de una persona con una infección viral, al igual que en la transmisión de madre a hijo durante el embarazo o el parto y entrando en contacto con superficies contaminadas. Además, como las bacterianas, las virales se pueden transmitir por la picadura de un insecto o por el consumo de alimentos o agua que estén contaminados.
Entre las virales más conocidas están la gripe, el resfriado comun, la gastroenteritis viral, la varicela, el sarampión, la meningitis viral, las verrugas, el virus de inmunodeficiencia humana (VIH), la hepatitis viral o el virus del Zika.
¿Un resfriado es bacteriano o viral?
Un resfriado puede causar congestión o secreción nasal, dolor de garganta y fiebre baja, pero ¿es bacteriano o viral? El resfriado común es causado por varios virus diferentes, aunque los rinovirus suelen ser los culpables. No hay mucho que se pueda hacer para tratar un resfriado, excepto esperar y usar medicamentos para ayudar a aliviar los síntomas.
En algunos casos, se puede desarrollar una infección bacteriana secundaria durante o después de un resfriado. Los casos comunes de infecciones bacterianas secundarias incluyen en los senos, en el oído o neumonía. Es posible que se haya desarrollado una infección bacteriana si los síntomas duran de 10 a 14 días o continúan empeorando en lugar de mejorar durante varios días. También si existe fiebre más alta de lo que normalmente se observa con un resfriado
¿Cómo se diagnostican las infecciones?
A veces, el médico puede diagnosticar una afección en función del historial médico y los síntomas. Por ejemplo, afecciones como el sarampión o la varicela tienen síntomas muy característicos que pueden diagnosticarse con un simple examen físico. Además, si hay una epidemia actual de una enfermedad en particular, el doctor lo tendrá en cuenta en el diagnóstico. Un ejemplo es la gripe, que causa epidemias estacionales en los meses fríos de cada año.
Si el médico quiere saber qué tipo de organismo puede estar causando una condición, puede tomar una muestra para cultivo. Las muestras que se pueden usar varían según la condición sospechada, pero pueden incluir sangre, moco o esputo u orina. Cuando se cultiva un microorganismo, permite a los investigadores identificar qué está causando una condición. En el caso de una infección bacteriana, también puede ayudarlos a determinar qué antibiótico puede ser útil para tratar la afección.
¿Qué infecciones se tratan con antibióticos?
Los antibióticos son medicamentos utilizados para tratar infecciones bacterianas. Existen muchos tipos diferentes, pero todos funcionan para evitar que las bacterias crezcan y se dividan de manera efectiva. No son efectivos contra las virales. La prescripción excesiva puede provocar resistencia, la cual ocurre cuando las bacterias se adaptan para poder resistir ciertos antibióticos.
¿Cómo se tratan las infecciones virales?
No existe un tratamiento específico para muchas infecciones virales. Generalmente se enfoca en el alivio de los síntomas mientras el cuerpo trabaja para eliminar la infección. Actos como beber líquidos para prevenir la deshidratación, descansar mucho, usar analgésicos como paracetamol o ibuprofeno para aliviar dolores, molestias y fiebre o tomar descongestionantes para ayudar con la secreción o congestión nasal.
Cómo prevenir infecciones
Estos son algunos de los consejos que se pueden seguir para ayudar a evitar enfermarse con una infección bacteriana o viral.
Practica buena higiene
Asegurarse de lavar las manos antes de comer, después de usar el baño y antes y después de manipular alimentos. Hay que evitar tocarse la cara, la boca o la nariz si las manos no están limpias. No compartir artículos personales como utensilios para comer, vasos o cepillos de dientes.
Vacunarse
Una multitud de vacunas están disponibles para ayudar a prevenir diversas enfermedades sea de un tipo u otro. Los ejemplos de enfermedades prevenibles por vacunación son el sarampión, la gripe, el tétanos o la tos ferina.
No salir si se está enfermo
Quedarse en casa si se padece una enfermedad de este tipo para ayudar a prevenir la propagación de la infección. Si hay que salir, lavarse las manos con frecuencia y estornudar o toser en la curva del codo o en un pañuelo. Asegurarse de deshacerse adecuadamente de los pañuelos usados.
Comida bien cocida
Es indispensable que todas las carnes estén cocidas a la temperatura adecuada. También lavar bien las frutas o verduras crudas antes de comerlas. Es crucial no permitir que los restos de comida permanezcan a temperatura ambiente y refrigerarlos de inmediato.